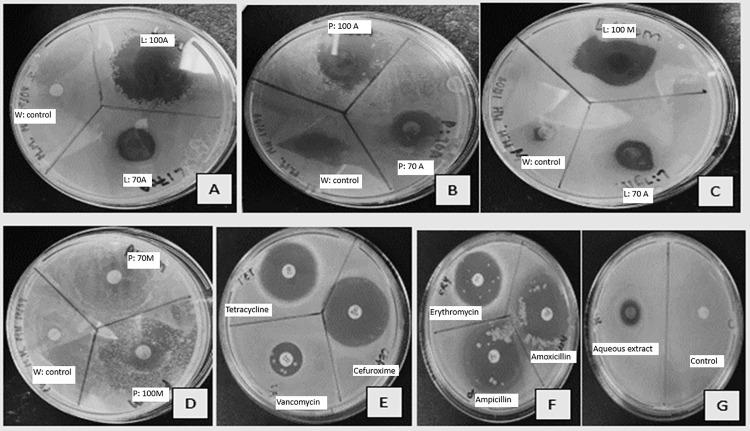
https://cdn.ncbi.nlm.nih.gov/pmc/blobs/2ef2/11975133/40185eb15573/pone.0321190.g003.jpg

番石榴(Psidium guajava)的定性植物化学分析及其体外抗菌和抗氧化活性
Qualitative phytochemical profiling, and in vitro antimicrobial and antioxidant activity of Psidium guajava (Guava).
作者信息
Möwes Mauricia, Kandanda Graça K, Nangolo Loide N, Shafodino Festus S, Mwapagha Lamech M
机构信息
Department of Biology, Chemistry and Physics, Faculty of Health, Natural Resources and Applied Sciences, Namibia University of Science and Technology, Private Bag, Windhoek, Namibia.
出版信息
PLoS One. 2025 Apr 7;20(4):e0321190. doi: 10.1371/journal.pone.0321190. eCollection 2025.
Psidium guajava is a well-known tropic tree, widely cultivated for its fruits, and traditionally, it has long been used for medicinal purposes. For instance, its fruit peels are also being used to alleviate stomach cramps in Namibia and its leaves-derived aqueous extract are used to treat Candidiasis (yeast infection) caused by Candida albicans in some parts of the world. Therefore, this study identified the phytochemical compounds in Psidium guajava leaf and fruit peels extracts, determined its antioxidant and antimicrobial activities. Psidium guajava leaves and fruit peels extracts were obtained using five solvents (Acetone, methanol, aqueous acetone, aqueous methanol and water) via maceration and boiling extraction methods. The extracts were then subjected to phytochemical screening, Gas chromatography-Mass spectrometry, Fourier Transform Infrared Spectroscopy, antioxidant, and antimicrobial analyses (against pathogenic bacteria: Escherichia coli, Salmonella spp., Staphylococcus aureus and fungus; Candida albicans). The qualitative phytochemical screening revealed the presence of alkaloids, flavonoids, phenols, tannins, steroids, saponins and terpenoids, and some of their associated functional groups were revealed by Fourier transform infrared spectroscopy analysis. Gas chromatography-Mass spectrometry analysis identified various compounds with antimicrobial and antioxidant properties. The different crude extracts exhibited varying inhibitory effects against the selected pathogens, with the leave extracts exhibiting the highest antimicrobial activity whereas, the peel extract exhibited the highest antioxidant activity. This study thus highlights Psidium guajava's intriguing therapeutic contribution towards the survival of humankind and it can be strategized for future use to treat pathogenic bacterial diseases.
番石榴是一种著名的热带树木,因其果实而被广泛种植,长期以来一直被用于药用。例如,在纳米比亚,其果皮被用于缓解胃痉挛;在世界一些地区,其叶提取物被用于治疗白色念珠菌引起的念珠菌病(酵母菌感染)。因此,本研究鉴定了番石榴叶和果皮提取物中的植物化学成分,测定了其抗氧化和抗菌活性。通过浸渍和煮沸提取法,使用五种溶剂(丙酮、甲醇、丙酮水溶液、甲醇水溶液和水)获得了番石榴叶和果皮提取物。然后对提取物进行植物化学筛选、气相色谱-质谱分析、傅里叶变换红外光谱分析、抗氧化和抗菌分析(针对病原菌:大肠杆菌、沙门氏菌属、金黄色葡萄球菌和真菌;白色念珠菌)。定性植物化学筛选显示存在生物碱、黄酮类、酚类、单宁、甾体、皂苷和萜类化合物,傅里叶变换红外光谱分析揭示了其中一些相关的官能团。气相色谱-质谱分析鉴定了具有抗菌和抗氧化特性的各种化合物。不同的粗提物对所选病原体表现出不同的抑制作用,叶提取物表现出最高的抗菌活性,而果皮提取物表现出最高的抗氧化活性。因此,本研究突出了番石榴对人类生存的有趣治疗贡献,可为未来治疗病原菌疾病的应用制定策略。